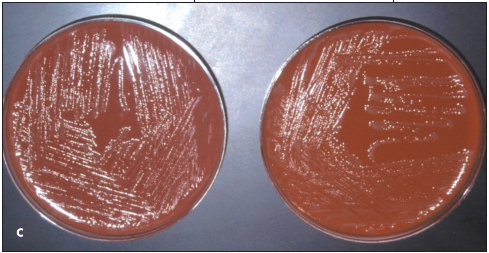
Disseminated Gonococcal Infection

Photo Essay: Sexually Transmitted Diseases
Secondary Syphilis, Case 1
A 55-year-old man presented with a widespread eruption that had gradually arisen during the preceding month. Except for the slightly pruritic lesions, the patient had no other symptoms. He was taking no new medications; he denied new sexual contacts and behaviors that increase the risk of HIV infection.
A widespread and uniform distribution of 3- to 5-mm, moderately firm, intradermal papules was found on the trunk and extremities; only the palms, soles, and intertriginous areas were spared. The photograph shows the right anterior axillary area of the chest and arm. No oral involvement or alopecia was noted. Laboratory test results showed no evidence of dyslipidemia, diabetes, or autoimmune diseases.
Biopsy results ruled out the differential diagnoses of granuloma annulare, sarcoidosis, eruptive xanthoma, and lichen planus. Histologic examination demonstrated numerous plasma cells, which raised the suspicion of syphilis. Presented with these data, the patient admitted to an extramarital heterosexual contact several months earlier. The results of the reactive plasma reagin and fluorescent treponemal antibody absorption tests and microhemagglutination assay for antibody to Treponema pallidum confirmed the diagnosis of syphilis. Intramuscular benzathine penicillin G, 2.4 million units, was given.
The patient was seronegative for HIV infection. He will be retested in several months.
___________________________________________________________________________________________________
Secondary Syphilis, Case 2
A 20-year-old woman complained of multiple nonpruritic lesions on her forearms and hands; the lesions had appeared suddenly, 2 weeks earlier. Examination revealed numerous erythematous annular macules and papules (A and B). A biopsy specimen showed scattered plasma cells, hyperkeratosis, parakeratosis, and aggregates of mononuclear cells in the papillary dermis. These findings favored a diagnosis of secondary syphilis, which was confirmed by a positive VDRL test. The patient was treated with a combination of penicillin G benzathine and penicillin G procaine, and the lesions resolved. However, follow-up will continue for several years to make sure that a complete cure is obtained.
Secondary syphilis is often called “the great imitator,” because it may be mistaken for pityriasis rosea, drug eruption, lichen planus, or numerous other skin disorders. Whenever syphilis is suspected, a VDRL test must be ordered.

________________________________________________________________________________________________________
Condyloma Latum
This 20-year-old woman has been HIV-seropositive for a year and recently has had Pneumocystis carinii pneumonia. Her recent complaint was of cough, fever, and shortness of breath. Incidental findings on examination were these large, pale, papular lesions in the vulvar area. The patient stated that she was just recovering from a “yeast infection.” Laboratory studies showed a positive reaction to the rapid plasma reagin test (titer, 1:32) as well as to the fluorescent treponemal antibody absorption test. On further questioning, the patient admitted that she had had previous treatment for syphilis, although she did not recall which antibiotic she had received.
Unlike the usual appearance of condyloma latum in secondary syphilis, some of these lesions were ulcerated. This may be a somewhat atypical presentation of syphilis in an HIV-seropositive patient.
________________________________________________________________________________________
Disseminated Gonococcal Infection
A 17-year-old girl, who reported having unprotected sexual intercourse, complained of lower abdominal pain; vaginal trichomoniasis was diagnosed. Metronidazole was given for 8 days, and the symptoms resolved. One week later, joint pain and skin lesions developed. Three weeks after the original diagnosis, the patient was admitted to the hospital with night sweats, fever, and a rash.
About 20 nontender pustules were noted on the patient’s hands, wrists, buttocks, and feet (A and B). Newly erupted lesions were seen on the soles; the patient had applied skin cream to an early pustule on the left sole. Joint tenderness was present in the left foot and knee and the right ankle. The white blood cell (WBC) count was 10,560/μL.
A clinical diagnosis of disseminated gonococcemia, or gonococcal arthritis–dermatitis syndrome, was made. Subsequently, blood and cervical cultures grew Neisseria gonorrhoeae on Thayer-Martin and chocolate agar media (C). Intravenous ceftriaxone, 1 g qd, and oral doxycycline, 100 mg q12h, were given; symptoms resolved within 48 hours.
Disseminated gonorrhea occurs in 0.5% to 3% of patients with gonorrhea. Untreated, asymptomatic primary disease is more common in women who are predisposed to gonococcal dissemination by menstruation and pregnancy.1,2
The pathogenesis of the gonococcal arthritis–dermatitis syndrome is unclear; however, bacteremia and immune complex formation have been demonstrated.3 Interestingly, the gonococci that cause disseminated infection are distinct from those that cause urethritis in that the former are resistant to complementmediated bactericidal activity.4
The gonococcal arthritis–dermatitis syndrome typically presents as a 3-week primary infection with joint pain, fever, and rash.2 Disseminated gonococcemia most commonly features a pauciarticular arthritis of the wrists, fingers, elbows, knees, and ankles. HIV-infected patients often have involvement of typically unaffected joints, such as the sternoclavicular and hip joints.1
About 50% of patients with disseminated infection have dermatitis. Typically, few (between 2 and 20) lesions erupt, mostly on the distal extremities. Erythematous pinpoint macules may progress to vesiculopustules, tender or necrotic papules, or hemorrhagic bullae. These lesions are thought to be microabscesses of the skin that are secondary to embolization of bacteria.5 The WBC count is usually minimally elevated, as in this patient.5

Generally, the diagnosis is made clinically; however, it is advisable to confirm the presence of the organism by culture isolation.2,3 Early in the disease course, blood cultures may be positive for gonococci, whereas cultures of skin lesions with chocolate agar and modified Thayer-Martin media are often negative.2,4 A DNA probe assay that is effective on a nonviable specimen can be used as an alternative to culture for diagnosis.6
Intravenous ceftriaxone for 2 or 3 days followed by an oral antibiotic, such as cefixime or ciprofloxacin—for a total of 1 week of treatment—is recommended. Alternative regimens are available for patients who are allergic to these agents. Symptoms typically resolve within 24 to 48 hours after therapy is initiated. Concomitant administration of doxycycline for Chlamydia infection is routine, since 50% of patients with disseminated gonococcemia are coinfected.2
Pelvic inflammatory disease is the most significant complication of gonococcal infection in women.4,5 Prompt diagnosis and treatment of the infection are essential to prevent infertility, ectopic pregnancy, and chronic pelvic pain. Chronic arthritis, perihepatitis (Fitz-Hugh and Curtis syndrome), endocarditis, and meningitis are rare complications.3
REFERENCES:
1. Angulo JM, Espinoza LR. Gonococcal arthritis. Compr Ther. 1999;25:155-162.
2. Brown TJ, Yen-Moore A, Tyring SK. An overview of sexually transmitted diseases: part 1. J Am Acad Dermatol. 1999;41:511-532.
3. Feingold DS, Peacocke M. Gonorrhea. In: Freedberg IM, Eisen AZ, Wolff K, et al, eds. Fitzpatrick’s Textbook of Dermatology in General Medicine. 5th ed. New York: McGraw-Hill; 1999:2598-2603.
4. Schoolnik GK, Buchanan TM, Hohnes KK. Gonococci causing disseminated gonococcal infection are resistant to the bactericidal action of normal human sera. J Clin Invest. 1976;58:1163-1173.
5. English JC, Monk JS. Gonococcal dermatitisarthritis syndrome. Am Fam Physician. 1986;34: 77-79.
6. Schwebke JR, Zajackowski ME. Comparison of DNA probe (Gen-Probe) with culture for the detection of Neisseria gonorrhoeae in an urban SID programme. Genitourin Med. 1996;72:108-110.
____________________________________________________________________________________________________
Condyloma Acuminata, Case 1
Between 15 and 20 large, asymptomatic, cauliflowerlike condylomata had been present for several years on the penile shaft of a 52-year-old uncircumcised man. The patient and practitioner were concerned about the oncogenous potential of the human papillomavirus (HPV) that causes these warts. The likelihood of penile condyloma transformation to squamous cell carcinoma is much greater in uncircumcised men than in those who have been circumcised. In addition, the patient feared transmitting HPV to his female partners; HPV infection increases the risk of cervical cancer in affected women.
The warts were removed by shave excision and electrodesiccation, as shown in the photograph. Histopathologic examination of tissue ruled out cellular atypia; reactive plasma reagent test results were negative for condyloma latum.
The patient was counseled about the high probability of wart recurrence and the need to treat the condylomata with liquid nitrogen several times a year to control the disease.
__________________________________________________________________________________________________
Condyloma Acuminatum, Case 2
A solitary polypoid lesion had been present for 6 months on the urethral meatus of a 24-year-old man. The patient and his wife, who was symptom-free, denied contact with anyone who had similar lesions.
The patient was given a local anesthetic, and the lesion was excised in the office. Microscopic examination of the tissue confirmed the diagnosis of condyloma acuminatum.
Genital warts are caused by several strains of the human papillomavirus (HPV) that are transmitted by sexual contact. Unlike the presentation in this patient, genital warts usually erupt in multiples and may be numerous. HPV types 16, 18, 31, 33, and 45 cause at least 85% of cervical cancers; the primary culprits, HPV types 16 and 18, are associated with the most pernicious cancers of the cervix.l,2 A controlled trial of an HPV type 16 vaccine showed promising results; women who received the vaccine were protected from cervical cancer and persistent genital tract infections, thereby precluding transmission of the virus to sex partners.1,3
Treatment options for genital warts include local excision; electrocauterization; cryotherapy with liquid nitrogen; and applications of podophyllum resin, 10% to 25%, trichloroacetic acid or bichloracetic acid, 80% to 90%, and intralesional interferon. Podofilox 0.5% solution or gel and imiquimod 5% cream may be administered by the patient. Topical trichloroacetic acid is the preferred chemical treatment for pregnant patients. Genital warts often recur after treatment.
This patient has had no recurrence since the lesion was excised. His wife was advised to seek medical evaluation and to remain alert for signs and symptoms of HPV infection.
REFERENCES:
1. Crum CP. The beginning of the end for cervical cancer? N Engl J Med. 2002;347:1703-1705.
2. Ryan KJ, Berkowitz RS, Barbieri RI. Dunaif A. Kistner’s Gynecology and Women’s Health. 7th ed. St Louis: Mosby; 1999:101.
3. Koutsky LA, Ault KA, Wheeler CM, et al. A controlled trial of a human papillomavirus type 16 vaccine. N Engl J Med. 2002;347:1645-1651.
________________________________________________________________________________________
Chancroid
A 32-year-old man had a 3-day history of a painful erosion on the penis accompanied by extremely tender “swelling” in the groin. He admitted to multiple episodes of unprotected sexual intercourse with prostitutes during the past month.
Physical examination revealed a 0.75-cm ulceration of the distal foreskin that was notably tender on palpation, and a 3.5-cm erythematous, tender, and fluctuant inguinal lymph node (A).

The working differential diagnosis included primary syphilis, chancroid, herpes progenitalis, and granuloma inguinale. The presence of pain and tenderness favored chancroid and herpes; the fluctuant node and lack of antecedent blisters suggested chancroid.
A serologic test result for syphilis (rapid plasma reagin) was negative, and a dark-field examination of the ulcer exudate failed to disclose spirochetes. A herpes culture was likewise negative. The enlarged lymph node was aspirated (B), and the acquired material was sent for culture. The patient was given oral erythromycin, 2 g/d. The grossly purulent nodal aspirate, as well as a specimen obtained by swabbing the ulcer base, grew abundant Haemophilus ducreyi, the causative organism of chancroid. All signs and symptoms cleared after 7 days of therapy.
Although relatively uncommon in the United States, chancroid is a frequent cause of infectious genital ulceration worldwide. Epidemics of this disorder have appeared intermittently in North America, and this patient proved to be the first of about 30 cases seen during the ensuing several months. Diagnosis is based on the exclusion of lues and herpes, and by demonstration of the causative organism on culture. However, many strains prove difficult to isolate on standard media and require enriched chocolate agar with vancomycin added to suppress contaminant overgrowth. Oral erythromycin and intramuscular ceftriaxone are the drugs of choice.

